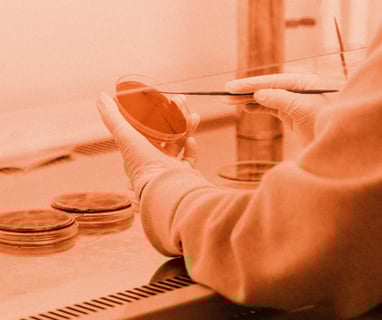

Your post title
MOVIE PRODUCTION

Suspendisse faucibus mauris massa, ut scelerisque est ultricies nec. Aliquam quis dictum tortor. Nunc tincidunt gravida ornare. Sed pulvinar faucibus dolor ac efficitur.
Praesent nisl est, rhoncus at augue sed, semper fermentum lacus. Nullam a suscipit turpis, a facilisis diam. Sed luctus in nibh eu laoreet. Pellentesque varius lacinia hendrerit. Nunc mauris nunc, dapibus sit amet ullamcorper vel, viverra sed arcu. Fusce eget urna ligula. Pellentesque rhoncus urna augue, et pretium nibh condimentum aliquam. Ut mollis semper purus, non volutpat mi sagittis ultricies. Pellentesque et velit non dolor elementum vestibulum. Nullam rutrum, lorem eu pharetra blandit, massa est eleifend lorem, auctor cursus mi orci non nisl. Donec fermentum maximus quam. Morbi ex mi, consequat eu lobortis sed, tempus vel sapien. Sed ultricies enim nec magna faucibus, eu consectetur arcu porttitor. Maecenas at libero aliquam, pulvinar lectus sed, hendrerit erat.
Vestibulum ante ipsum primis in faucibus orci luctus et ultrices posuere cubilia curae; Sed tellus velit, aliquet in egestas faucibus, sagittis at sem. Quisque tristique lectus eget odio interdum convallis. Quisque sit amet ultricies ipsum. Phasellus id lorem vitae nibh tincidunt finibus. Duis nec maximus eros, et euismod ipsum. Suspendisse mollis a nisl vitae tempus. In varius imperdiet arcu sagittis consequat. Nulla interdum laoreet lorem sed placerat.
Morbi sollicitudin nunc sapien. Nunc nec massa lacus. Vestibulum at sem vitae purus blandit scelerisque varius quis velit. Mauris in leo quis arcu tempus feugiat in quis enim. Nullam non lectus eget enim accumsan vehicula. Vivamus iaculis pretium suscipit. Cras mattis, elit sed ullamcorper euismod, dolor sapien tincidunt est, eget mollis mauris elit et dui. Curabitur convallis, nisl mollis auctor consequat, leo enim lobortis arcu, a efficitur lorem dolor non erat. Pellentesque vel libero sit amet lorem placerat volutpat. Ut dignissim elementum arcu ut eleifend.
Maecenas consequat at erat in accumsan. Nulla lorem libero, viverra eget pellentesque pulvinar, elementum eu ligula. Vivamus id tempus eros. Class aptent taciti sociosqu ad litora torquent per conubia nostra, per inceptos himenaeos. Praesent porttitor, nulla ut porta luctus, risus tortor tempus leo, sit amet gravida velit erat tempus dui. Nam quis diam neque. Duis faucibus vehicula purus. Phasellus ante erat, tincidunt quis aliquet ac, sodales eu eros. In hac habitasse platea dictumst. Proin eget posuere justo. Duis efficitur, eros non scelerisque ultricies, massa eros rhoncus lacus, at rhoncus tortor leo volutpat dolor.
Suspendisse elit neque, euismod eu lacus a, fringilla interdum mi. Vestibulum at egestas ligula. Morbi aliquet tellus vel felis dignissim, sit amet vulputate diam fringilla. Lorem ipsum dolor sit amet, consectetur adipiscing elit. Ut gravida elit eleifend lectus pretium porttitor. Nulla hendrerit, sem a lobortis laoreet, tellus purus viverra neque, non varius sapien dolor eget augue. Interdum et malesuada fames ac ante ipsum primis in faucibus. Nulla sollicitudin eros id odio tempus, eu dignissim elit pulvinar.
